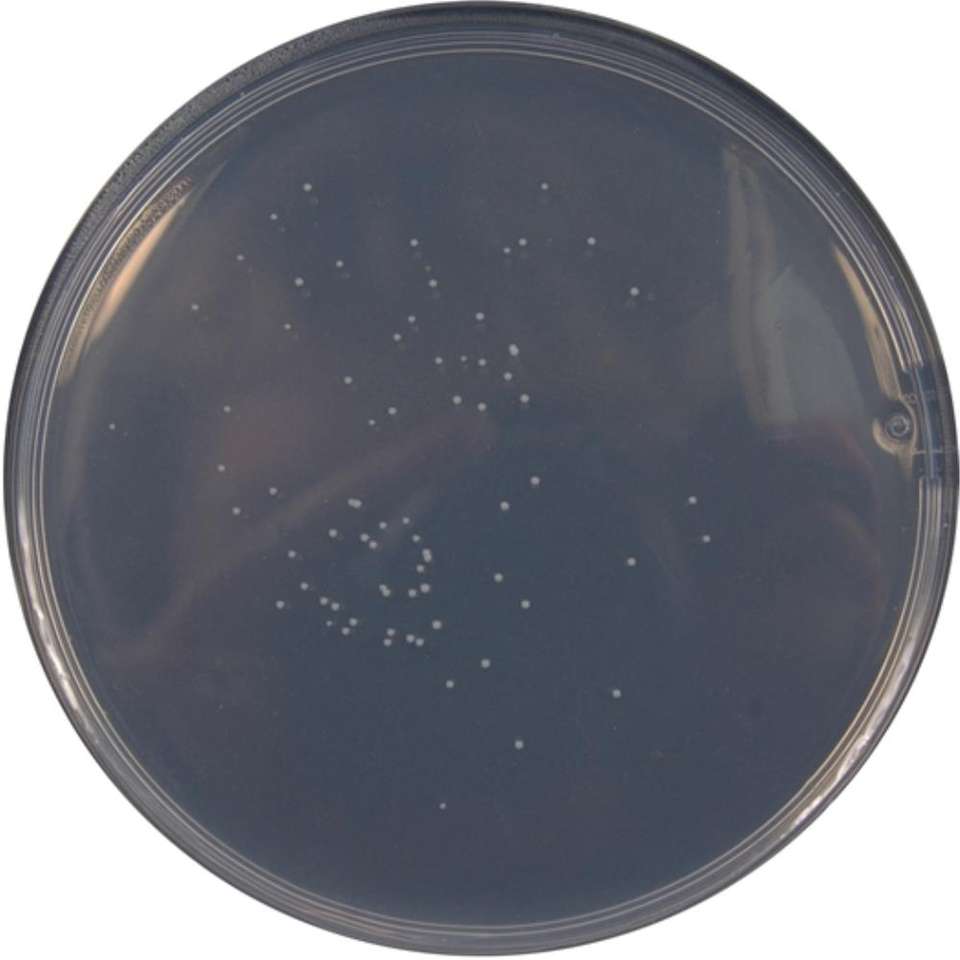

Attributi
PK10Unit Size
MED1262Code

Ogni pagamento che effettui su Alibaba.com è protetto da una rigorosa crittografia SSL e dai protocolli di protezione dei dati PCI DSS.

Richiedi un rimborso se il tuo ordine non viene spedito, è smarrito o arriva con problemi relativi al prodotto